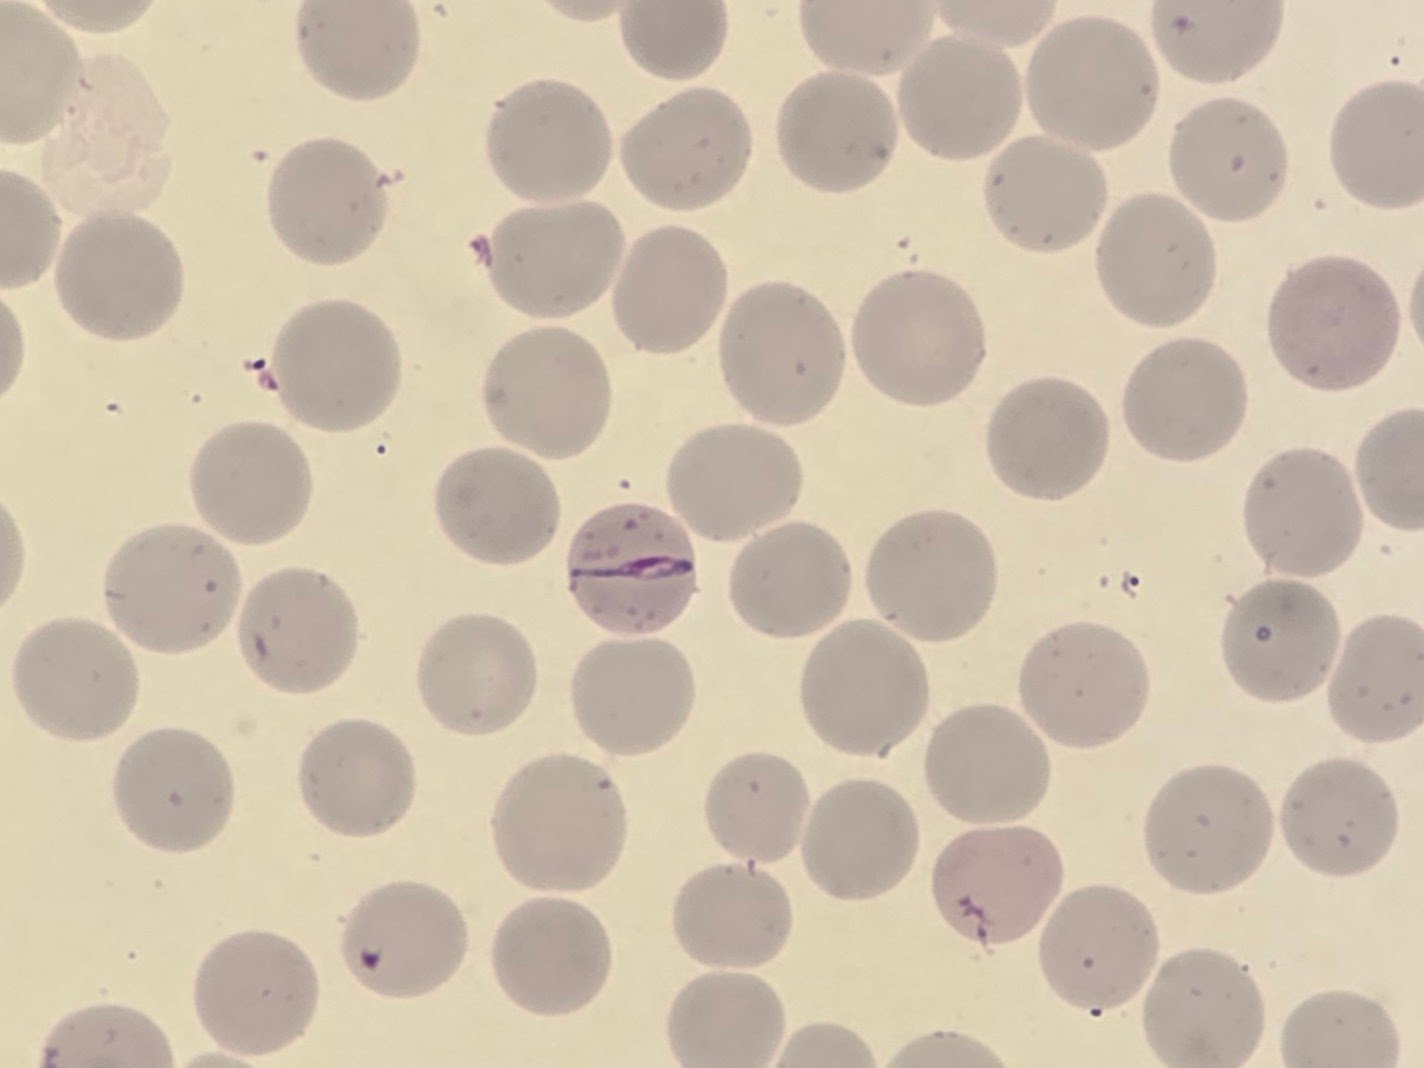

This peripheral blood smear comes from a man in his 30s who had recently returned from Cameroon without taking malaria prophylaxis.
A rapid diagnostic test (RDT) using the CareUS Malaria kit returned positive T1 and T2 lines. This pattern is significant:
- T1 detects P. falciparum-specific antigen
- T2 detects pan-Plasmodium antigen
Together, this strongly suggests Plasmodium falciparum infection.
On the film, note the single infected red cell near the centre, displaying a striking band-like form — a morphology more commonly associated with P. malariae. However, in this case, further features point to P. falciparum, including the presence of Maurer’s clefts and the travel history.
This case is a reminder that parasite morphology isn’t always textbook. While band forms are classically linked to P. malariae, morphological overlap can occur, and a confident diagnosis often requires correlation with clinical, geographic, and RDT findings.
One Comment
That was a tough one! As someone who doesn’t look at much malaria the one way I guessed falcip was the mauer’s clefts.